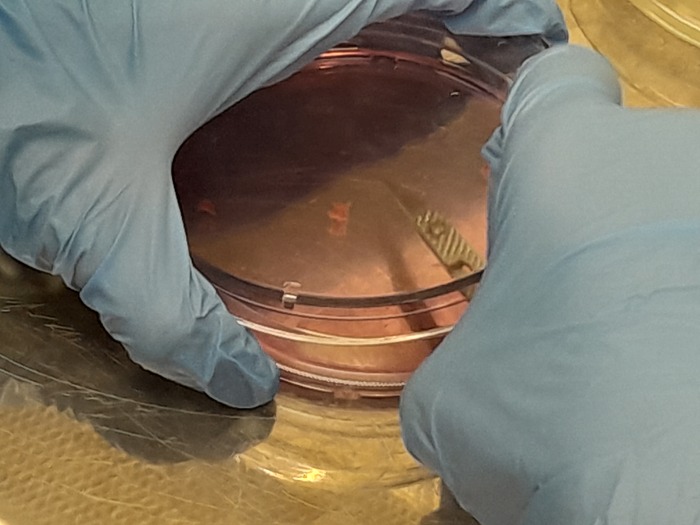

Искусственный интеллект взломал код жизни: созданная им ДНК впервые управляет генами в клетках млекопитающих
Учёные из Центра геномного регулирования в Испании совершили прорыв в биологии: искусственный интеллект создал молекулы ДНК, которые впервые успешно управляют генами в здоровых клетках млекопитающих. ИИ разработал искусственные фрагменты ДНК, которые могут включать или выключать гены в нужных клетках, например, заставлять стволовые клетки превращаться в клетки крови. Это как программирование для живых организмов.
ИИ создал инструмент, который генерирует новые последовательности ДНК — цепочки из «букв» (A, T, C, G), называемые энхансерами. Эти фрагменты длиной около 250 букв управляют экспрессией генов, то есть определяют, какие гены будут активны в конкретных клетках. Например, ИИ может создать энхансер, который включит ген, превращающий стволовые клетки в эритроциты (клетки крови), но не в тромбоциты (клетки, отвечающие за свертывание крови).
Ученые синтезировали эти фрагменты химически и с помощью вируса доставили их в клетки крови мышей. В экспериментах ДНК интегрировалась в геном клеток в случайных местах. ИИ спроектировал энхансеры, которые активировали ген, кодирующий флуоресцентный белок, чтобы ученые могли видеть, работает ли система. Результаты были точными: гены включались в нужных клетках, не затрагивая другие.
Доктор Роберт Фромель, первый автор исследования, сравнил процесс с написанием программ для биологии: «Это дает невероятную точность в управлении клетками». Технология может изменить лечение болезней, связанных с нарушением работы генов, таких как рак или аутоиммунные расстройства. ИИ позволяет создавать энхансеры, которых нет в природе, и настраивать их так, чтобы они работали только в определенных клетках, минимизируя побочные эффекты.
Чтобы создать такие молекулы, ИИ нужно «научить» языку клеток. Энхансеры — это как грамматические правила, управляющие генами. Ученые собрали огромный объем данных, изучив тысячи экспериментов на клетках крови. Они исследовали, как энхансеры и белки (факторы транскрипции) взаимодействуют, чтобы включать или выключать гены. За пять лет команда синтезировала более 64 тысяч искусственных энхансеров — это самая большая коллекция такого рода.
Ученые отслеживали, как энхансеры работают на семи стадиях развития клеток крови. Большинство из них действовали как регуляторы громкости, усиливая или ослабляя активность генов. Но некоторые комбинации работали как выключатели: два фактора, которые обычно включают ген, вместе его выключали. Это явление, названное «отрицательной синергией», удивило ученых. Данные помогли ИИ предсказывать, какие новые энхансеры дадут нужный эффект, даже если их никогда не существовало в природе.
Технология может привести к созданию новых методов лечения, где гены пациентов будут настраиваться с высокой точностью. Например, можно будет активировать гены, борющиеся с болезнью, только в больных клетках. Однако для этого нужны большие объемы данных и дальнейшие исследования. Доктор Ларс Вельтен, соавтор, отметил: «Мы расшифровали язык клеток, чтобы писать новые инструкции для них».
Исследователи планируют усовершенствовать ИИ, чтобы он создавал еще более сложные энхансеры. Это открытие — шаг к персонализированной медицине и пониманию того, как клетки работают на молекулярном уровне. Оно также показывает, как ИИ может стать помощником в биологии, создавая решения, которых природа еще не придумала.
Автор: Dexter
Источник: IXBT
Оригинал: CRG